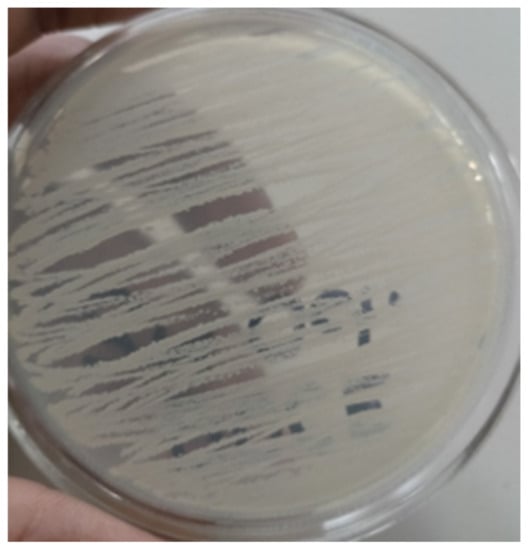

Abstract
The goal of this study is to improve concrete’s efficiency by using a microbiologically produced specific growth/filler. One such way of thinking has resulted in the invention of a highly unusual concrete known as microbial concrete, which uses bacteria to cure flaws in the concrete. Investigators working with various microorganisms suggested several microbial concretes. The bacterium “Pseudomonas” was used in this experiment. Pseudomonas bacteria, which can make calcite precipitates on a proper medium supplied with a calcium supply, is a typical science lab bacterium for calcite generation. Two different concentrations (106 cfu/mL and 107 cfu/mL) of bacteria were added to cement concrete and it was observed that the bacterial concrete with two different concentrations gives results as compared with normal concrete. According to the findings of this investigation, the inclusion of bacteria resulted in a considerable increase in compressive strength when the dilution factor was 106 cells per ml of mixed water. With the incorporation of the microorganisms, it was discovered that holes were partly filled up by material growth, as shown by scanning electron micrography inspection of the sample. Concrete cubes without and with the inclusion of bacteria were molded, and it was discovered that the compressive strength of the cubes with the injection of microorganisms increased significantly. In this study, concrete cylinders without and with the inclusion of microorganisms were molded, and it was discovered that the split tensile strength of the cylinders with the injection of microorganisms increased significantly above the control. When compared with regular concrete, the results showed a maximum increase of 16 percent in compressive strength and a maximum increase of 12 percent in split tensile strength. It was discovered via durability testing that bacterial concrete had less weight loss and stronger tensile strength than conventional concrete when treated with 5 percent H2SO4 or 5 percent MgSO4 compared with control concrete.
1. Introduction
Concrete is the building material employed in the vast majority of construction projects [1,2]. Despite the fact that it may be used in a wide variety of building applications, it is widely acknowledged to have a number of drawbacks. It has a low ductility, is not very resistant to breaking, and has a low tension-bearing capacity. As a result of the ongoing research carried out in different parts of the world, numerous improvements have been made on a regular basis in order to compensate for the shortcomings of cement concrete [3,4,5]. The continuing research in the field of concrete technology has contributed to the growth of specialized concrete that takes into consideration the speed at which construction can be completed, the strength properties, the durability properties, as well as the environmental protection of concrete by using industrial materials such as metakaolin, silica fume, blast furnace slag, fly ash, and other such materials [6,7]. For compression loads, concrete has a high load-bearing capability; yet, the substance is feeble under tension. It is for this reason that steel reinforcing bars are implanted in the material in order to construct structures. When the concrete fractures under strain, the rebar’s take over and carry the weight. Rebars are protected from corrosion by the concrete, which shields them from the elements and prevents them from corroding themselves. The fissures in the concrete, on the other hand, are a source of concern [8,9,10]. One of the reasons for preventing cracks or limiting crack widths is to ensure long-term durability. Other factors to consider are the water resistance of structures, the lack of stiffness, and other human perceptions. If a reliable technique for automatically repairing cracks in concrete could be established, it would significantly enhance and assure the durability and usefulness of the method for automatically repairing cracks in concrete that developed. It would, on either side, save a significant amount of money. As consequence, the number of cracks that occur in concrete structures that need to be repaired would decrease [11]. However, it is likely that a significant amount of the excess steel utilized to control fracture widths may be saved as well [12,13].
Fracture widths in civil infrastructure should be kept to a minimum, mostly for reasons of longevity. If the fracture thicknesses are very big, the cracks must be fixed or more reinforcements must be included in the design [14,15]. An automated approach for crack control in concrete might save a tremendous amount of money, including both terms of the expenses of injecting fluids into cracks as well as the price of additional steel that is added to buildings only for the purpose of limiting the breadth of cracks [16]. This additional steel is completely pointless because of structural considerations [17,18]. A reliable self-healing technology for concrete would pave the foundations for a successful approach to the construction of long-lasting concrete buildings, which would be advantageous to both the national and international economies [11,19,20].
Recent research has shown that the general behavior of concrete can be enhanced by the presence of bacterial mineral precipitation, which is caused by the metabolic functions of beneficial microorganisms in cementitious materials. The action may take place either in or out of the bacterial membrane, or it may even take place some distance away inside the concrete. In many cases, the actions of bacteria do nothing more than cause a change in the chemical composition of the solution, which then results in the saturation of the solution to an excessive level and the precipitation of minerals. When applied to concrete, these biological ideas lead to the creation of a potentially groundbreaking new material known as bacterial concrete. The “microbial concrete” may be created by incorporating microorganisms into the cementitious materials that are capable of precipitating calcite on a continuous basis. Microbiologically generated calcite precipitation is the term used to describe this process. Because of the vast variety of research and engineering consequences of (calcium carbonate) CaCO3 precipitation, which is a common process among microorganisms, it has been extensively researched. In the research lab, calcite generation is accomplished by Pseudomonas, a model bacterium that can create calcite precipitates on proper medium that has been supplied with calcium [21,22]. Pseudomonas, a common soil microbe, was utilized to generate CaCO3 deposition in the laboratory. Based on the fundamental concepts of urease hydrolysis, which produces carbon dioxide and ammonia, as well as the subsequent rise in pH caused by the ammonia discharged into the atmosphere, leading to a buildup of refractory CaCO3, such application has been developed and implemented [23,24]. The favorable circumstances do not naturally present in a concrete, but must be developed in order to be realized. This will be the subject of a significant portion of the study. So, how could the ideal circumstances be established for the bacterium to not only live in concrete, but also thrive and generate as much calcite as is required to mend fractures in the concrete? Additionally, the microorganisms should be maintained in a certain dosage in a particular medium before they can be mixed into the concrete materials to ensure that they are not killed. In this case, optimization is required, which entails experimental investigation [25,26,27].
On the bacterial concrete, many investigators have investigated the influence of two types of bacteria, B. pasteurii and B. sphaericus, on the concrete’s bacterial content [28,29]. In any event, only a limited amount of study has been conducted on various kinds of microorganisms. Pseudomonas Bacteria are now being investigated to see if they are suitable for usage in concrete. A study has also been conducted to determine the effect of microorganisms on the strength and durability of concrete. The current investigation demonstrates that the incorporation of bio-mineralization elements into cementitious composites may be a viable technique for improving the strength properties of cementitious composites.
2. Materials and Methods
2.1. Cement, Sand, Aggregate, and Water
This research made use of ordinary Portland cement 43 grade, which was tested in accordance with Indian Standard Specifications code IS 4031-1988. It was also constructed using natural sand that was tested in accordance with Indian Standard Specifications IS 383-1970, with the maximum sizes for fine and coarse aggregates being 4.75 mm and 20 mm, correspondingly. M 30 grade concrete was used in this research work and concrete materials based on M 30 grade concrete were used.
2.2. Pseudomonas Bacteria
The Bacillus Pseudomonas Bacteria strain utilized in this research was acquired from the Department of Biotechnology at GLA University in Mathura and used in this investigation.
2.3. Culturing Process of Bacteria
An isolated Bacillus Pseudomonas Bacteria strain was inoculated in nutrient broth media and cultivated at 37 °C in a mechanical shaker for one day to achieve the late exponential phase [30]. An isolated culture of microbes from the Department of Biotechnology at GLA University, Mathura was used in this study, and it was kept alive on nutrient agar slants on a continuous basis. On the nutrient agar, the colony developed in an irregular white pattern. When a single colony of the culture is required, it is immunized into a nutritional solution of 25 mL in a 100 mL tapered flask and allowed to grow. In this configuration, the temperature should be maintained at 30 degrees Celsius [31,32], and the apparatus is rotated at 125 revolutions per minute. The development of bacteria culture was aided by the addition of peptone gram per liter, sodium chloride gram per liter, and yeast extract gram per liter [33,34]. Figure 1 shows the Growth of Pseudomonas Bacteria.
Figure 1.
Growth of Pseudomonas Bacteria.
For this research work, two concentrations of Pseudomonas Bacteria were tested in 106 cf/mL and 107 cf/mL. The following equation was used to calculate the cell concentration in the sample: Equation (1) [7]
where x = OD reading and y = the number of bacterial cells present in one milliliter of solution.
Gram Staining
When performing Gram-staining, the technique involves spreading a new culture of bacteria onto an empty microscope slide and allowing the culture to dry naturally before fixing it with a little amount of heat. For one minute, the slide was submerged in gentian violet solution. Afterwards, the slide was gently cleaned with treated water for 2–3 s before being submerged for one minute in an iodine solution [35]. The slide was cleaned once again and then delayed with 95 percent ethanol until no more stain could be seen running off the surface [36,37]. Afterward, the slide was cleaned once more and resuspended for 10 s with safranin, after which it was washed and allow to dry with a paper towel. Gram-positive cells are shown by the color blue, whereas Gram-negative cells are represented by the color red. Gram-positive cells that are more than a decade old might seem intermediate or even red. Figure 2 shows the Gram staining result.

Figure 2.
Gram staining result.
2.4. Compressive Strength
The compression strength test was carried out on cubes of 100 mm × 100 mm × 100 mm, and the casting was carried out in accordance with Indian Standard Specifications code IS 516 1959. It was necessary to cast all of the concrete specimen at room temperature. The compressive strength of the microbial concrete samples was determined according to IS code 516-1959 [38] at 28, 56, 90, and 180 days after curing.
2.5. Split Tensile Strength
The split tensile strength of concrete test was 100 mm × 200 mm. All of the specimens’ casting was done according to Indian Standard Specifications code IS 516 1959 [38]. Figure 3 shows the compression and tension strength test.

Figure 3.
Mechanical strength test setup. (a) Compressive Strength test on Cube. (b) Split Tensile Strength test on cylinder. (c) Compression testing machine.
After compressive and tensile test of bacterial concrete, the broken parts of concrete were observed. The cracked pattern of concrete cubes suggested that concrete cubes break unevenly, and the broken pattern of concrete cylinders suggested that very small cracks are produced in the concrete cylinder near the notch [39,40]. Figure 4 shows the crack pattern after compression and tension strength test.

Figure 4.
Crack pattern after Mechanical strength test. (a) Failure after Compressive Strength test on Cube. (b) Failure after Split Tensile Strength test on cylinder.
2.6. Acid Attack and Sulphate Attack
The concrete cube was immersed in a solution consisting of sulfuric acid and magnesium sulphate for a specified period of time. A solution of 5% sulfuric acid and 5% magnesium sulphate in 1000 mL of tap water was poured into two different containers. The solution of 5% sulfuric acid and 5% magnesium sulphate was changed at intervals of 7 days, 21 days, 28 days, and 56 days. The loss in weight of samples was mostly examined after the samples degraded. Some studies have also shown that variations in compressive strength may be used as an indication of corrosion. Durning and Hicks subjected concrete samples to seven-day assault cycles using H2SO4 solutions containing 1 percent and 5 percent H2SO4, respectively. After each cycle, the samples were cleaned and weighed to ensure accuracy. They looked into the influence of silica fume deposition on the ability to withstand H2SO4 exposure. In this study, it was discovered that, as the quantity of silica fume in the cement grew (from 0 percent to 30 percent by weight of the cement), the resistance of the specimens increased as well. It was found that, with a 30 percent replacement, there was a sharp increase in the number of compounding periods of the samples in the 1 percent H2SO4 solution [41].
3. Discussion of Test Results
3.1. Effect of Bacterial Solution on Compressive Strength and Split Tensile Strength
It is demonstrated in Figure 5 that bacterial concrete has better compressive strength and split tensile strength than normal concrete. Bacterial cultures are very effective in precipitating calcium carbonate in concrete. When compared with regular concrete, it is noticed that the compressive strength grew by a maximum of 16 percent and the split tensile strength increased by a maximum of 12 percent. Because calcium lactate remains in the same state after curing, the compressive strength of concrete containing solely calcium lactate will be lower than the compressive strength of concrete incorporating microorganisms. It is also important to note that calcium carbonate is not formed only by the formation of calcium lactate; rather, it is converted to CaCO3 by microorganisms. The strength of the concrete may be improved as a result of this.

Figure 5.
Compressive and tensile strength.
3.2. Effect of H2SO4 and MgSO4 Attack on Pseudomonas Bacterial Concrete
The presence of microorganisms in concrete results in the precipitation of CaCO3 within the voids of the concrete, which has the effect of increasing the strength of the concrete while simultaneously reducing its permeability. Biomineralization is the process that produces CaCO3, which assists in the gain of strength, water permeability, decreases water absorption, sulfate resistance, and acid attack. It is beneficial to use microbes in concrete because they are environmentally friendly, increase strength, seal concrete fractures without the need for any external intervention, are resistant to freeze–thaw cycles, have a lower permeability, have a good durability, reduce deterioration of reinforced concrete, and help to reduce repair and maintenance costs. Bio concrete has a low permeability coefficient and a strong acid durability index, which makes it less susceptible to erosion and less likely to require costly repairs. These properties provide an edge to bacterial concrete in the industrial sector. Figure 6 depicts the visual aspect of the samples after being exposed to MgSO4 and H2SO4 solutions for 28 days, 56 days, and 90 days. H2SO4 acid degrades concrete in a short period of time and in huge volumes. Because of the stress concentration produced by the crystal growth of ettringite, as illustrated in Figure 6, the specimens’ corners and edges were damaged more severely and depicted obvious spalling. This was attributed to the stress concentration generated by the crystallization of ettringite. For example, in addition to the visible damage around the edges and corners of the bacterial concrete specimens, the original face of the samples was degraded as a result of the microbes. At various ages, the loss in weight and the loss in compressive strength were calculated, as shown in Figure 7 and Figure 8. It was shown that the inclusion of bacteria results in a lower percentage mass loss and mechanical properties than without the microorganisms.

Figure 6.
Effect of acid and sulphate attack on bacterial concrete with different intervals days. Image 1 (a) Bacterial concrete sample after 28 days, (b) MgSO4 cured sample 28 days + 28 days, and (c) crack pattern after 28 days + 28 days MgSO4 cured sample. Image 2 (a) Bacterial concrete sample after 56 days, (b) MgSO4 cured sample 56 days + 28 days, and (c) crack pattern after 56 days + 28 days MgSO4 cured sample. Image 3 (a) Bacterial concrete sample after 90 days, (b) MgSO4 cured sample 90 days + 28 days, and (c) crack pattern after 90 days + 28 days MgSO4 cured sample. Image 4 (a) Bacterial concrete sample after 28 days, (b) H2SO4 cured sample 28 days + 28 days, and (c) crack pattern after 28 days + 28 days H2SO4 cured sample. Image 5 (a) Bacterial concrete sample after 28 days, (b) H2SO4 cured sample 56 days + 28 days, and (c) crack pattern after 56 days + 28 days H2SO4 cured sample. Image 6 (a) Bacterial concrete sample after 28 days, (b) H2SO4 cured sample 90 days + 28 days, and (c) crack pattern after 90 days + 28 days H2SO4 cured sample.

Figure 7.
Effect of acid attack on bacterial concrete with different interval days.

Figure 8.
Effect of sulphate attack on bacterial concrete with different interval days.
3.3. Scanning Electronic Microscopy (SEM)
As shown in Figure 9 Image 1a and Figure 10 Image 2a, the SEM analysis picture for control concrete taken at a magnification of 25,000 and a sub-acceleration voltage of 15,000 V clearly demonstrates the microstructure of ordinary concrete. The SEM picture of Pseudomonas microbial concrete with a magnification of 25,000 and a sub acceleration voltage of 15,000 V was taken with a scanning electron microscope. Microstructural analysis of the microbial concrete is shown in Figure 9 Image 1b,c and Figure 10 Image 2b,c, The pictures obtained from the SEM examination demonstrate the presence of calcite precipitation in the Pseudomonas microbial concrete. Pores, CSH, and CH were found in all of the specimens. Calcite was discovered in the pores of microbial concrete, which is a rare occurrence. It clearly demonstrates that calcite development causes the porosity to drop and the strength to increase, as well as the healing of fractures.

Figure 9.
SEM image of conventional concrete and bacterial concrete for 28 days. Image 1 (a) conventional concrete sample after 28 days, Image 1 (b) 106 cf/mL Pseudomonas Bacterial concrete after 28 days, and Image 1 (c) 107 cf/mL Pseudomonas Bacterial concrete after 28 days.

Figure 10.
SEM image of conventional concrete and bacterial concrete for 180 days. Image 2 (a) conventional concrete sample after 180 days, Image 2 (b) 106 cf/mL Pseudomonas Bacterial concrete after 180 days, and Image 2 (c) 107 cf/mL Pseudomonas Bacterial concrete after 180 days.
The scanning electron microscopy results of the concrete showed that the concrete was more dense at 180 days than at 28 days. It was also found that bacterial concrete was much denser than ordinary concrete. Image 1a of Figure 9 found that, after 28 days, the concrete had micro-cracks and gaps with high volume, but in Image 1b of Figure 9, it was found that the cracks and gaps in the 106 cfu/mL concrete were heavily filled. Similarly, in Images 1b,c of Figure 9, it is seen that the cracks and gaps in the 107 cfu/mL concrete were filled to a greater extent than in the 106 cfu/mL concrete. Moreover, as shown in Figure 10, Pseudomonas Bacterial concrete becomes more dense in 180 days than in 28 days, and it is seen in Images 1b,c of Figure 10 that the cracks and gaps in 107 cfu/mL concrete are filled to a greater extent than in 106 cfu/mL concrete.
4. Conclusions
Higher results were observed for the compressive strength of the Pseudomonas Bacterial concrete at all ages when using either of two different percentages of the bacterial solution. When compared with conventional concrete, the mechanical characteristics of bacterial concrete have shown a consistent upward trend throughout the course of all ages. The hydrated structure of cement mortar is improved when Pseudomonas Bacteria are included in the mix. According to the findings of an SEM study, the creation of calcium carbonate in any and all bacterial concrete mixes is beneficial to the healing of fractures. Based on the results of the durability tests, the percentage weight loss and percentage strength loss with 5% H2SO4 and 5% MgSO4 showed that bacterial concrete has a lower rate of weight and strength losses compared with conventional concrete.
Author Contributions
Conceptualization: A.S., N.G., S.D., N.I.V. and M.G.; Data curation, A.S., N.G., S.D., N.I.V. and M.G.; Formal analysis, S.D., N.I.V. and M.G.; Funding acquisition, N.G.; Investigation, A.S., N.G., S.D., N.I.V. and M.G.; Methodology, A.S., N.G., S.D., N.I.V. and M.G.; Software, M.G.; Supervision, N.G., N.I.V. and M.G.; Validation, S.D.; Writing—original draft, A.S., N.G. and S.D.; Writing—review & editing, S.D., N.I.V., M.G., K.K.S. and C.P. All authors have read and agreed to the published version of the manuscript.
Funding
The research was funded by the Ministry of Science and Higher Education of the Russian Federation as the grant Self-Healing Construction Materials (contract No. 075-15-2021-590 dated 04.06.2021.
Institutional Review Board Statement
Not applicable.
Informed Consent Statement
Not applicable.
Data Availability Statement
Not applicable.
Conflicts of Interest
The authors declare no conflict of interest.
References
- Kim, H.J.; Eom, H.J.; Park, C.; Jung, J.; Shin, B.; Kim, W.; Chung, N.; Choi, I.-G.; Park, W. Calcium carbonate precipitation by Bacillus and Sporosarcina strains isolated from concrete and analysis of the bacterial community of concrete. J. Microbiol. Biotechnol. 2015, 26, 540–548. [Google Scholar] [CrossRef] [PubMed] [Green Version]
- Shukla, A.; Gupta, N.; Kishore, K. Experimental investigation on the effect of steel fiber embedded in marble dust based concrete. Mater. Today Proc. 2020, 26, 2938–2945. [Google Scholar] [CrossRef]
- Lee, Y.S.; Kim, H.J.; Park, W. Non-ureolytic calcium carbonate precipitation by Lysinibacillus sp. YS11 isolated from the rhizosphere of Miscanthus sacchariflorus. J. Microbiol. 2017, 55, 440–447. [Google Scholar] [CrossRef] [PubMed]
- Sarkar, M.; Adak, D.; Tamang, A.; Chattopadhyay, B.; Mandal, S. Genetically-enriched microbe-facilitated self-healing concrete—A sustainable material for a new generation of construction technology. RSC Adv. 2015, 5, 105363–105371. [Google Scholar] [CrossRef]
- Talaiekhozan, A.; Fulazzaky, M.A.; Keyvanfar, A.; Andalib, R.; Zaimi, M.; Majid, A. Identification of gaps to conduct a study on biological self-healing concrete. J. Environ. Treat. Tech. 2013, 1, 62–68. [Google Scholar]
- Ahdash, A.I.S. Zeolite/Polyaniline Based Self-Healing and Silicon Oxide Coatings for Microbially Induced Corrosion Inhibition. Ph.D. Thesis, Universiti Teknologi Malaysia, Skudai, Malaysia, 2016. [Google Scholar]
- Manikandan, A.T.; Padmavathi, A. An experimental investigation on improvement of concrete serviceability by using bacterial mineral precipitation. Int. J. Res. Sci. Innov. 2015, 2, 46–49. [Google Scholar]
- Erşan, Y.Ç; Hernandez-Sanabria, E.; Boon, N.; de Belie, N. Enhanced crack closure performance of microbial mortar through nitrate reduction. Cem. Concr. Compos. 2016, 70, 159–170. [Google Scholar] [CrossRef]
- Wang, J.Y.; De Belie, N.; Verstraete, W. Diatomaceous earth as a protective vehicle for bacteria applied for self-healing concrete. J. Ind. Microbiol. Biotechnol. 2012, 39, 567–577. [Google Scholar] [CrossRef] [PubMed]
- Erşan, Y.Ç.; Boon, N.; Belie, N.D. Microbial self-healing concrete: Denitrification as an enhanced and environment-friendly approach. In Proceedings of the 5th International Conference on Self-Healing Materials, Durham, NC, USA, 22–24 June 2015. [Google Scholar]
- Chattopadhyay, B. Genetically-enriched microbe-facilitated self-healing nano-concrete. In Smart Nanoconcretes and Cement-Based Materials: Properties, Modelling and Applications; Elsevier Inc.: Amsterdam, The Netherlands, 2019. [Google Scholar] [CrossRef]
- Alazhari, M.; Sharma, T.; Heath, A.; Cooper, R.; Paine, K. Application of expanded perlite encapsulated bacteria and growth media for self-healing concrete. Constr. Build. Mater. 2018, 160, 610–619. [Google Scholar] [CrossRef]
- De Belie, N.; Wang, J. Bacteria-based repair and self-healing of concrete. J. Sustain. Cem.-Based Mater. 2015, 5, 35–56. [Google Scholar] [CrossRef]
- Schreiberová, H.; Kohoutková, A.; Bílý, P.; Ryparová, P. Bio-based self-healing concrete: A review. In Proceedings of the 12th Fib International PhD Symposium in Civil Engineering, Prague, Czech Republic, 29–31 August 2018; pp. 1169–1176. [Google Scholar]
- Sharma, P. A study on self-healing mechanism of microcracks in concrete structures using bacillus bacteria. Int. J. Sci. Res. Sci. Eng. Technol. 2016, 2, 6–13. [Google Scholar]
- Santos, R.P.; Ramos, T.M.; Borges, B.M.; Hollanda, L.M.; Lima, Á.S.; Soares, C.M.F.; Souza, R.L. A selected bacterial strain for the self-healing process in cementitious specimens without cell immobilization steps. Bioprocess Biosyst. Eng. 2021, 44, 195–208. [Google Scholar] [CrossRef] [PubMed]
- Sharma, N.; Sharma, P. Effect of hydrophobic agent in cement and concrete: A Review. IOP Conf. Ser. Mater. Sci. Eng. 2021, 1116, 012175. [Google Scholar] [CrossRef]
- Parashar, A.K.; Gupta, A. Investigation of the effect of bagasse ash, hooked steel fibers and glass fibers on the mechanical properties of concrete. Mater. Today Proc. 2021, 44, 801–807. [Google Scholar] [CrossRef]
- Shaheen, N.; Khushnood, R.A.; Khaliq, W.; Murtaza, H.; Iqbal, R.; Khan, M.H. Synthesis and characterization of bio-immobilized nano/micro inert and reactive additives for feasibility investigation in self-healing concrete. Constr. Build. Mater. 2019, 226, 492–506. [Google Scholar] [CrossRef]
- De Belie, N. Application of bacteria in concrete: A critical evaluation of the current status. RILEM Tech. Lett. 2016, 1, 56. [Google Scholar] [CrossRef] [Green Version]
- Souradeep, G.; Kua, H.W. Encapsulation technology and techniques in self-healing concrete. J. Mater. Civ. Eng. 2016, 28, 04016165. [Google Scholar] [CrossRef]
- Erşan, Y.Ç. Self-healing performance of biogranule containing microbial self-healing concrete under intermittent wet/dry cycles. J. Polytech. 2020, 24, 323–332. [Google Scholar] [CrossRef]
- Jakubovskis, R.; Jankutė, A.; Urbonavičius, J.; Gribniak, V. Analysis of mechanical performance and durability of self-healing biological concrete. Constr. Build. Mater. 2020, 260, 119822. [Google Scholar] [CrossRef]
- Mohammed, H.; Ortoneda-Pedrola, M.; Nakouti, I.; Bras, A. Experimental characterisation of non-encapsulated bio-based concrete with self-healing capacity. Constr. Build. Mater. 2020, 256, 119411. [Google Scholar] [CrossRef]
- Shukla, A.; Gupta, N. Study on the efficacy of natural pozzolans in cement mortar. In Calcined Clays for Sustainable Concrete; Springer: Berlin/Heidelberg, Germany, 2020; pp. 469–480. [Google Scholar] [CrossRef]
- Gupta, N.; Gupta, A.; Saxena, K.K.; Shukla, A.; Goyal, S.K. Mechanical and durability properties of geopolymer concrete composite at varying superplasticizer dosage. Mater. Today Proc. 2021, 44, 12–16. [Google Scholar] [CrossRef]
- Jena, S.; Panda, K.C. Effect of bacteria on the properties of concrete—A review. In Proceedings of the UKIERI Concrete Congress: Concrete: The Global Builder, Jalandhar, India, 5–8 March 2019. [Google Scholar]
- Jayaprakash, J. In Advances in Construction Materials and system. In Proceedings of the International Conference (ICACMS), Chennai, India, 3–8 September 2017. [Google Scholar]
- Lee, Y.S.; Park, W. Current challenges and future directions for bacterial self-healing concrete. Appl. Microbiol. Biotechnol. 2018, 102, 3059–3070. [Google Scholar] [CrossRef] [PubMed]
- Joshi, S.; Goyal, S.; Mukherjee, A.; Reddy, M.S. Microbial healing of cracks in concrete: A review. J. Ind. Microbiol. Biotechnol. 2017, 44, 1511–1525. [Google Scholar] [CrossRef] [PubMed]
- Gupta, S.G.; Rathi, C.; Kapur, S. Biologically induced self healing concrete: A futuristic solution for crack repair. Int. J. Appl. Sci. Biotechnol. 2013, 1, 85–89. [Google Scholar] [CrossRef] [Green Version]
- Ryu, Y.; Lee, K.-E.; Cha, I.-T.; Park, W. Optimization of bacterial sporulation using economic nutrient for self-healing concrete. J. Microbiol. 2020, 58, 288–296. [Google Scholar] [CrossRef] [PubMed]
- Kiranmaye, B.R.; Dutta, J.R.; Kar, A.; Parimi, C.; Raju, S. Optimization of culture parameters of Pseudomonas alcaligenes for crack healing in concrete. Mater. Today Proc. 2019, 28, 713–716. [Google Scholar] [CrossRef]
- Erşan, Y.C.; Akın, Y. Optimizing nutrient content of microbial self-healing concrete. In Life-Cycle Analysis and Assessment in Civil Engineering: Towards an Integrated Vision—Proceedings of the 6th International Symposium on Life-Cycle Civil Engineering, IALCCE 2018, Ghent, Belgium, 28–31 October 2018; CRC Press: Boca Raton, FL, USA, 2018; pp. 2241–2246. [Google Scholar]
- Nonakaran, S.H.; Pazhouhandeh, M.; Keyvani, A.; Abdollahipour, F.Z.; Shirzad, A. Isolation and identification of Pseudomonas azotoformans for induced calcite precipitation. World J. Microbiol. Biotechnol. 2015, 31, 1993–2001. [Google Scholar] [CrossRef]
- Parashar, A.K.; Gupta, A. Effects of the concentration of various bacillus family bacteria on the strength and durability properties of concrete: A Review. IOP Conf. Ser. Mater. Sci. Eng. 2021, 1116, 012162. [Google Scholar] [CrossRef]
- Parashar, A.K.; Gupta, A. Experimental study of the effect of bacillus megaterium bacteria on cement concrete. IOP Conf. Ser. Mater. Sci. Eng. 2021, 1116, 012168. [Google Scholar] [CrossRef]
- IS 516; Method of Tests for Strength of Concrete. Bureau of Indian Standards: New Dehli, India, 2018. [CrossRef]
- Paknahad, A.; Kucko, N.W.; Leeuwenburgh, S.C.; Sluys, L.J. Experimental and numerical analysis on bending and tensile failure behavior of calcium phosphate cements. J. Mech. Behav. Biomed. Mater. 2020, 103, 103565. [Google Scholar] [CrossRef]
- Paknahad, A.; Goudarzi, M.; Kucko, N.W.; Leeuwenburgh, S.C.G.; Sluys, L.J. Calcium phosphate cement reinforced with poly (vinyl alcohol) fibers: An experimental and numerical failure analysis. Acta Biomater. 2021, 119, 458–471. [Google Scholar] [CrossRef] [PubMed]
- Erşan, Y.Ç; Verbruggen, H.; De Graeve, I.; Verstraete, W.; De Belie, N.; Boon, N. Nitrate reducing CaCO3 precipitating bacteria survive in mortar and inhibit steel corrosion. Cem. Concr. Res. 2016, 83, 19–30. [Google Scholar] [CrossRef]
Publisher’s Note: MDPI stays neutral with regard to jurisdictional claims in published maps and institutional affiliations. |
© 2022 by the authors. Licensee MDPI, Basel, Switzerland. This article is an open access article distributed under the terms and conditions of the Creative Commons Attribution (CC BY) license (https://creativecommons.org/licenses/by/4.0/).